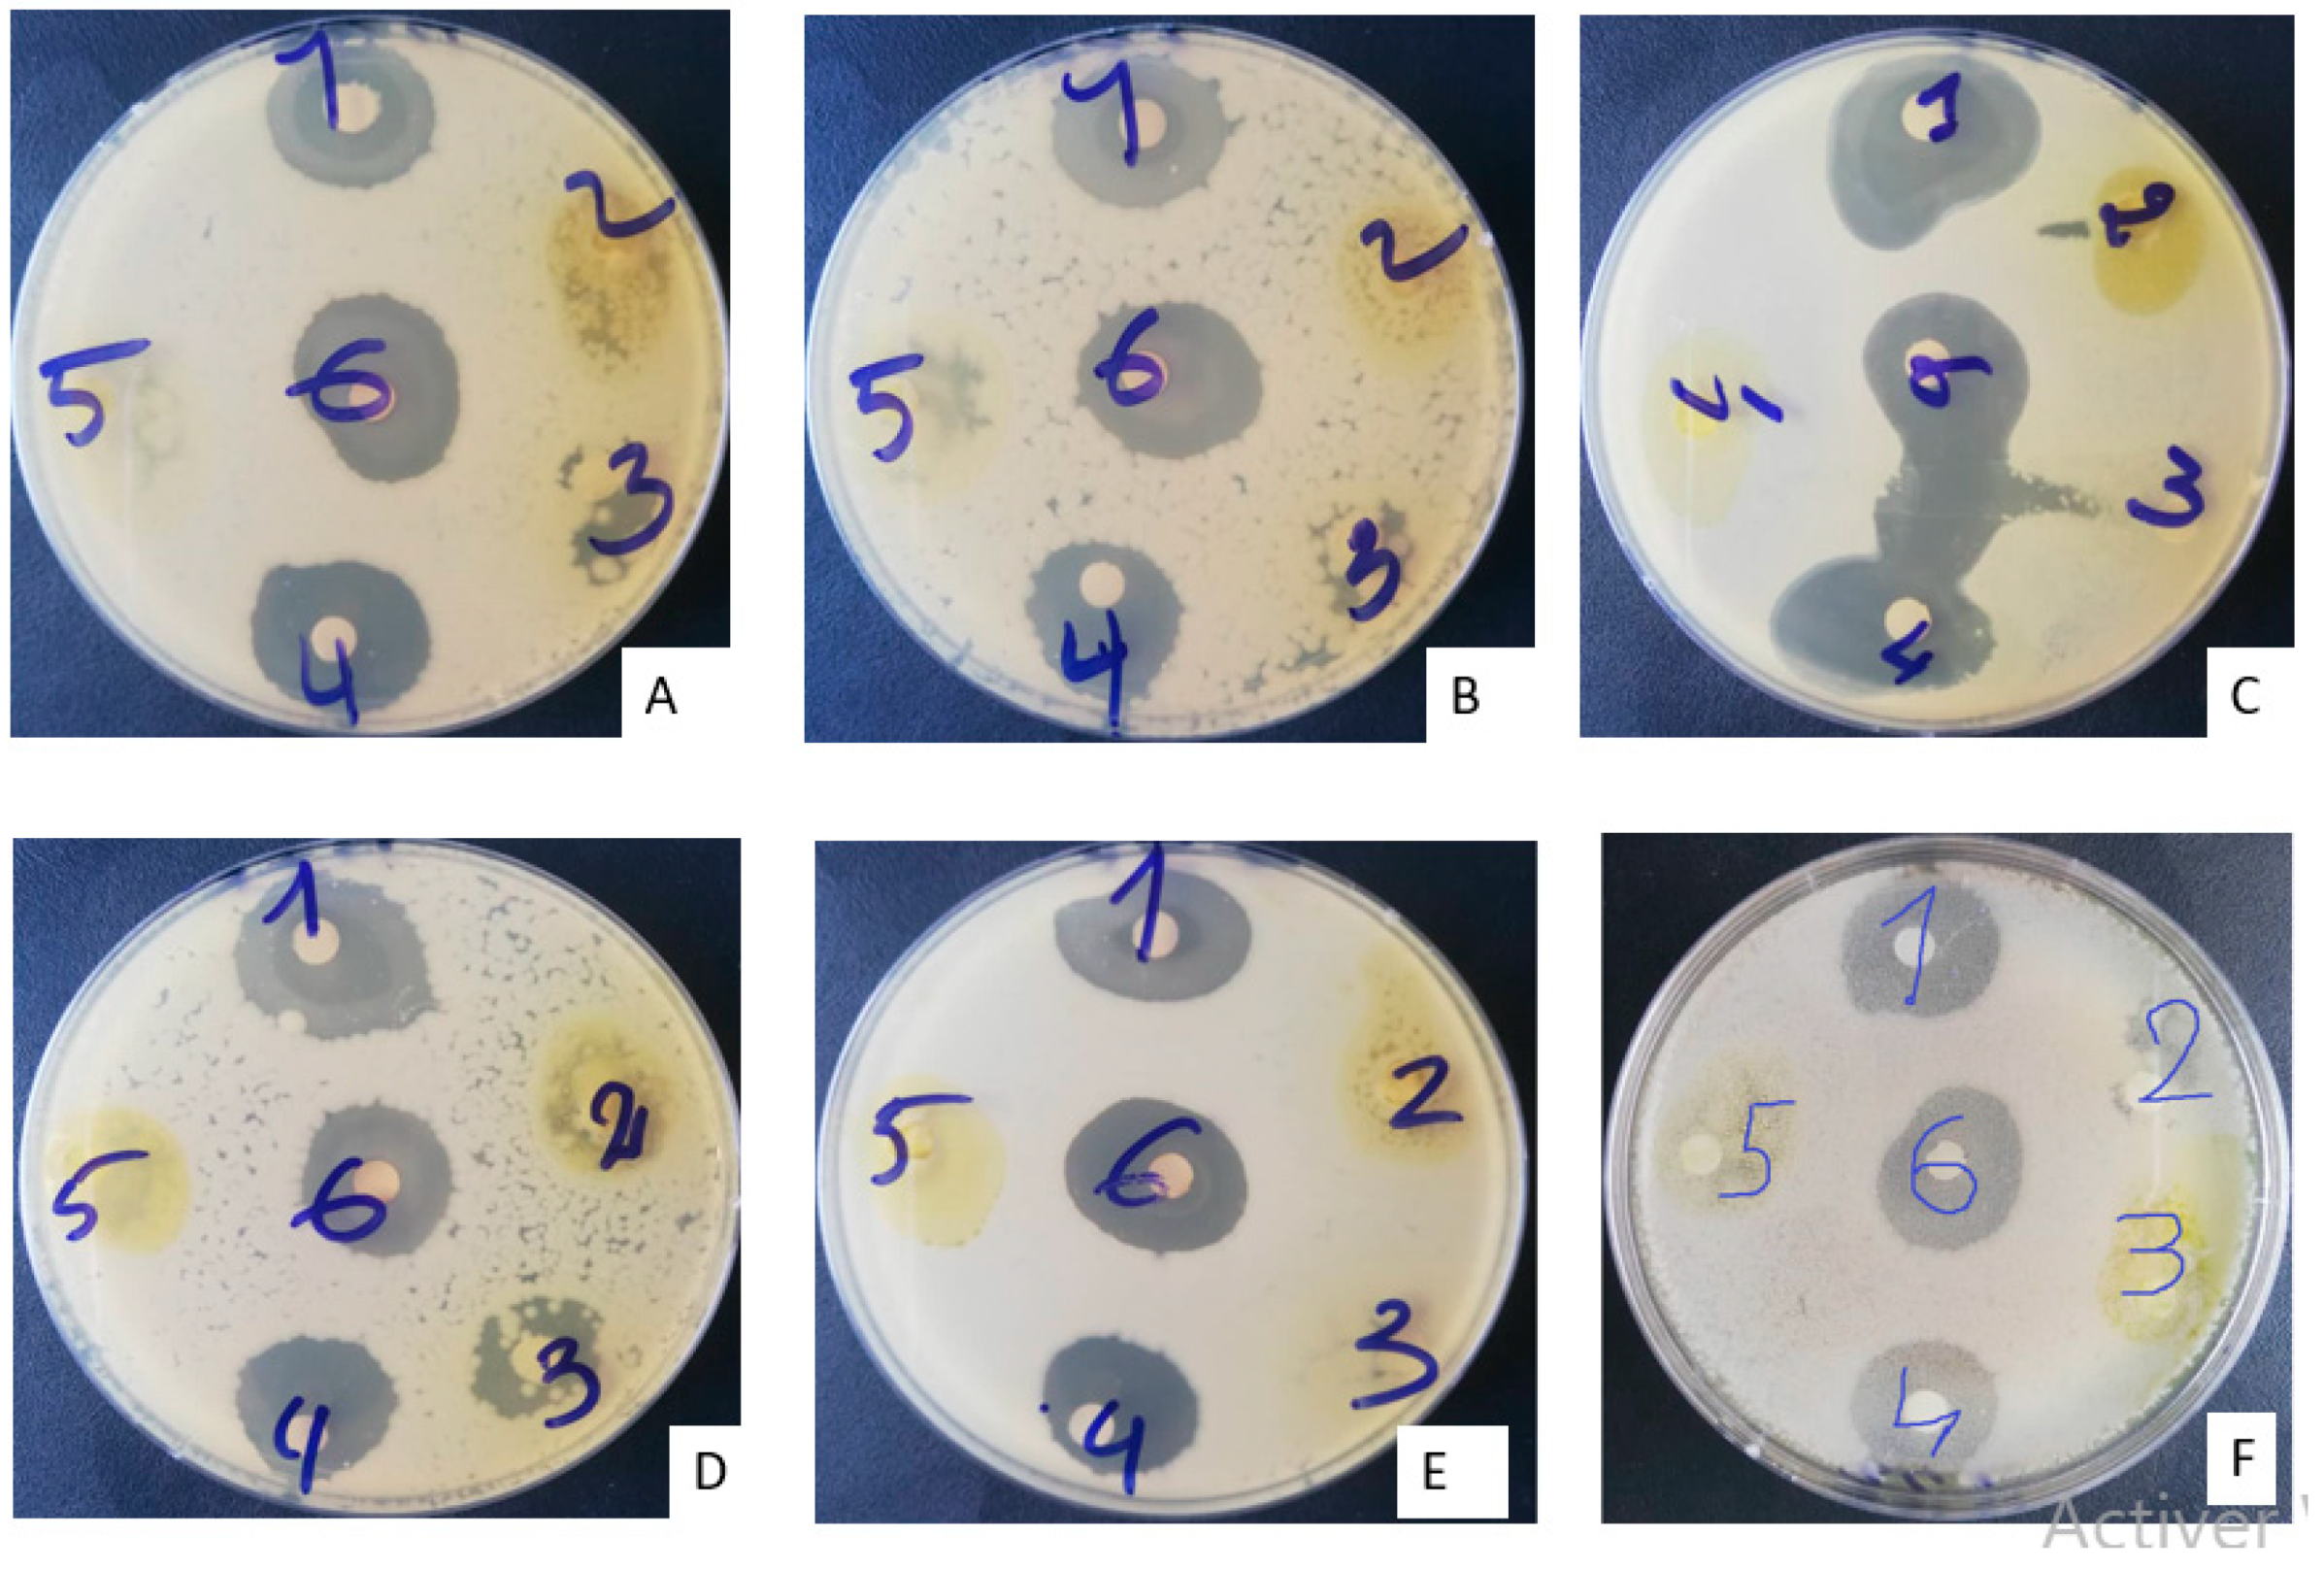

Mung Bean (Vigna radiata (L.) R. Wilczek) from Burkina Faso Used as Antidiabetic, Antioxidant and Antimicrobial Agent
Abstract
1. Introduction
2. Results
2.1. Phytochemical Screening
2.2. Antimicrobial Activity
2.2.1. Sensitivity Testing of Microbial Strains (Antibiogram)
2.2.2. Minimum Inhibitory Concentrations (MICs) and Minimum Bactericidal Concentrations (MBCs)
2.3. Antioxidant Activity of Extracts
2.4. Antidiabetic Activities of Extracts
2.4.1. Changes in Blood Glucose and Body Weight
2.4.2. Antihyperglycemic Effect of Mung Bean Extracts
Evolution of Blood Glucose during Treatment
Effect of Extracts on Weight Evolution
Biochemical Parameters
- Blood function: Blood Count (CBC)
Lipid Profile
Liver Function
Renal Function
Pearson Linear Correlation
2.4.3. Histopathology
3. Discussion
4. Materials and Methods
4.1. Sample Preparation
4.2. Phytochemical Screening
4.3. Preparation of Extracts
4.4. Evaluation of the Antimicrobial Activity of Extracts
4.4.1. Preparation of the Preculture and the Antibiogram
4.4.2. Determination of the Minimum Inhibitory Concentration (MIC) and the Minimum Bactericidal Concentration (MBC)
4.5. Evaluation of the Antioxidant Activity of Different Extracts
4.6. In Vivo Antihyperglycemic Activity of Extracts
4.6.1. Induction of Diabetes by Streptozotocin
4.6.2. Treatment of Diabetic Rats
4.6.3. Determination of Biochemical Parameters
4.7. Statistical Analysis
5. Conclusions
Author Contributions
Funding
Institutional Review Board Statement
Informed Consent Statement
Data Availability Statement
Acknowledgments
Conflicts of Interest
References
- Gutiérrez, R.P.; Muñiz-Ramirez, A.; Garcia-Campoy, A.; Flores, J.M. Evaluation of the Antidiabetic Potential of Extracts of Urtica dioica, Apium graveolens, and Zingiber officinale in Mice, Zebrafish, and Pancreatic β-Cell. Plants 2021, 10, 1438. [Google Scholar] [CrossRef] [PubMed]
- Méril-Mamert, V.; Ponce-Mora, A.; Sylvestre, M.; Lawrence, G.; Bejarano, E.; Cebrián-Torrejón, G. Antidiabetic Potential of Plants from the Caribbean Basin. Plants 2022, 11, 1360. [Google Scholar] [CrossRef] [PubMed]
- Saeedi, P.; Petersohn, I.; Salpea, P.; Malanda, B.; Karuranga, S.; Unwin, N.; Colagiuri, S.; Guariguata, L.; Motala, A.A.; Ogurtsova, K.; et al. Global and regional diabetes prevalence estimates for 2019 and projections for 2030 and 2045: Results from the International Diabetes Federation Diabetes Atlas, 9(th) edition. Diabetes Res. Clin. Pract. 2019, 157, 107843. [Google Scholar] [CrossRef] [PubMed]
- Victoria, H.; Reimar, W.; Ole, H.; Nicoli, L. Diabetes in Sub Saharan Africa 1999-2011: Epidemiology and public health implications. a systematic review. BMC Public Health 2019, 11, 1471–2458. [Google Scholar]
- Wu, S.-J.; Wang, J.-S.; Lin, C.-C.; Chang, C.-H. Evaluation of hepatoprotective activity of legumes. Int. J. Phyther. Phytopharm. 2001, 8, 213–219. [Google Scholar] [CrossRef]
- Hou, D.; Chen, J.; Ren, X.; Wang, C.; Diao, X.; Hu, X.; Zhang, Y.; Shen, Q. A whole foxtail millet diet reduces blood pressure in subjects with mild hypertension. J. Cereal Sci. 2018, 84, 13–19. [Google Scholar] [CrossRef]
- Lamri-senhadji, M.; Bouchenak, M. Legumes and health benefits. Nutr. Santé 2013, 2, 3–8. [Google Scholar] [CrossRef]
- Ramesh, C.K.; Rehman, A.; Prabhakar, B.T.; Avin, B.R.V.; Rao, S.J.A. Antioxidant potentials in sprouts vs. seeds of vigna radiata and macrotyloma uniflorum. J. Appl. Pharm. Sci. 2011, 1, 99–103. Available online: https://www.researchgate.net/publication/264057578 (accessed on 22 September 2021).
- Zhu, W.; Li, S.; Li, J.; Jundoria, A.; Sama, A.E.; Wang, H. It Is Not Just Folklore: The Aqueous Extract of Mung Bean Coat Is Protective against Sepsis. Evid.-Based Complement. Altern. Med. 2012, 2012, 1–10. [Google Scholar] [CrossRef]
- Tiwari, U.; Servan, A.; Nigam, D. Comparative study on antioxidant activity, phytochemical analysis and mineral composition of the Mung Bean (Vigna radiata) and its sprouts. J. Pharmacogn. Phytochem. 2017, 6, 336–340. [Google Scholar]
- Tang, D.; Dong, Y.; Ren, H.; Li, L.; He, C. A review of phytochemistry, metabolite changes, and medicinal uses of the common food mung bean and its sprouts (Vigna radiata). Chem. Cent. J. 2014, 8, 1–9. [Google Scholar] [CrossRef] [PubMed]
- Jang, Y.-H.; Kang, M.-J.; Choe, E.-O.; Shin, M.; Kim, J.-I. Mung bean coat ameliorates hyperglycemia and the antioxidant status in type 2 diabetic db/db mice. Food Sci. Biotechnol. 2013, 23, 247–252. [Google Scholar] [CrossRef]
- Lee, J.H.; Jeon, J.K.; Kim, S.G.; Kim, S.H.; Chun, T.; Imm, J.Y. Comparative analyses of total phenols, flavonoids, saponins and antioxidant activity in yellow soy beans and mung beans. Int. J. Food Sci. Technol. 2011, 46, 2513–2519. [Google Scholar] [CrossRef]
- Singh, N.; Mishra, N.; Chaurasia, S. Antioxidant Activity of Total, Free and Bound Phenolics from Raw and Sprouted Mung Beans. Int. J. Recent Biotechnol. 2014, 2, 1–8. Available online: https://www.ijrbp.com (accessed on 22 September 2021).
- Amare, Y.E.; Dires, K.; Asfaw, T. Antidiabetic Activity of Mung Bean or Vigna radiata (L.) Wilczek Seeds in Alloxan-Induced Diabetic Mice. Evid.-Based Complement. Altern. Med. 2022, 2022, 6990263. [Google Scholar] [CrossRef]
- Kabré, J.D.W.; Hama-Ba, F.; Sawadogo, A.Y.; Cissé, H.; Traoré, Y.; Savadogo, A. Biological Activities of Beng-tigré (Vigna radiata): Nutritional Aspects and Therapeutic Functions. Am. J. Food Sci. Technol. 2021, 9, 113–124. [Google Scholar] [CrossRef]
- Luo, J.; Cai, W.; Wu, T.; Xu, B. Phytochemical distribution in hull and cotyledon of adzuki bean (Vigna angularis L.) and mung bean (Vigna radiate L.) and their contribution to antioxidant, anti-inflammatory, and antidiabetic activities. Food Chem. 2016, 201, 350–360. [Google Scholar] [CrossRef]
- Xu, B.; Chang, S.K. Comparative study on antiproliferation properties and cellular antioxidant activities of commonly consumed food legumes against nine human cancer cells. Food. Chem. 2012, 134, 1287–1296. [Google Scholar] [CrossRef]
- Egbuna, V.K.; Ezzat, C.; Tijjani, S.M.; Srivastav, H. Synthetic analogs of phytochemicals. In Phytochemistry: An In-Silico In-Vitro Updat; Springer: Singapore, 2019; pp. 23–55. [Google Scholar]
- Yao, Y.; Yang, X.; Tian, J.; Liu, C.; Cheng, X.; Ren, G. Antioxidant and antidiabetic activities of black mung bean (Vigna radiata L.). J. Agric. Food Chem. 2013, 61, 8104–8109. [Google Scholar] [CrossRef]
- Hayase, F.; Kato, H. Antioxidative Components of Sweet Potatoes. J. Nutr. Sci. Vitaminol. 1984, 30, 37–46. [Google Scholar] [CrossRef]
- Stavric, B.; Matula, T.I. Flavonoids in Foods: Their Significance for Nutrition and Health. In Lipid-Soluble Antioxidants: Biochemistry and Clinical Applications; Springer: Berlin, Germany, 1992; pp. 274–294. [Google Scholar] [CrossRef]
- Xie, J.; Du, M.; Shen, M.; Wu, T.; Lin, L. Physico-chemical properties, antioxidant activities and angiotensin-I converting enzyme inhibitory of protein hydrolysates from Mung bean (Vigna radiate). Food Chem. 2017, 270, 243–250. [Google Scholar] [CrossRef] [PubMed]
- Kim, D.K.; Jeong, S.C.; Gorinstein, S.; Chon, S.U. Total Polyphenols, Antioxidant and Antiproliferative Activities of Different Extracts in Mungbean Seeds and Sprouts. Plant Foods Hum. Nutr. 2012, 67, 71–75. [Google Scholar] [CrossRef] [PubMed]
- Randhir, K.; Lin, R.; Shetty, Y.T. Stimulation of phenolics, antioxidant and antimicrobial activities in dark germinated mung bean sprouts in response to peptide and phytochemical elicitors. Process Biochem. 2004, 39, 637–646. [Google Scholar] [CrossRef]
- Bellik, Y.; Hammoudi, S.M.; Abdellah, F.; Iguer-Ouada, M.; Boukraa, L. Phytochemicals to Prevent Inflammation and Allergy. Recent Pat. Inflamm. Allergy Drug Discov. 2012, 6, 147–158. [Google Scholar] [CrossRef]
- Koehler, P.; Hartmann, G.; Wieser, H.; Rychlik, M. Changes of folates, dietary fiber, and proteins in wheat as affected by germination. J. Agric. Food Chem. 2007, 55, 4678–4683. [Google Scholar] [CrossRef]
- Wang, S.; Ng, T.B.; Chen, T.; Lin, D.; Wu, J.; Rao, P. First report of a novel plant lysozyme with both antifungal and antibacterial activities. In Biochemical and Biophysical Research; Elsevier: Amsterdam, The Netherlands, 2005; pp. 820–827. [Google Scholar] [CrossRef]
- Hafidh, R.R.; Abdulamir, A.S.; Bakar, F.A.; Sekawi, Z.; Jahansheri, F.; Jalilian, F.A. Novel antiviral activity of mung bean sprouts against respiratory syncytial virus and herpes simplex virus -1: An in vitro study on virally infected Vero and MRC-5 cell lines. BMC Complement. Altern. Med. 2015, 15, 1–16. [Google Scholar] [CrossRef]
- Kabré, W.J.D.; Dah-Nouvlessounon, D.; Hama, F.; Kohonou, N.A.; Sina, H.; Senou, M.; Baba-Moussa, L.; Savadogo, A. Anti-Inflammatory and Anti-Colon Cancer Activities of Mung Bean Grown in Burkina Faso. Evid.-Based Complement. Altern. Med. 2022, 2022, 7873572. [Google Scholar] [CrossRef]
- Eliza, P.; Rajalakshmi, J.; Ignacimuthu, M.; Daisy, S.J. Normalizing effects of Costus speciosus rhizome crude extracts and its fractions on diabetic complications in STZ-induced diabetic rats. Med. Chem. Res. 2011, 20, 1111–1118. [Google Scholar] [CrossRef]
- Eidi, E.; Eidi, A.; Esmaeili, M. Antidiabetic effect of garlic (Allium sativum L.) in normal and streptozotocin-induced diabetic rats. Phytomedicine 2006, 13, 624–629. [Google Scholar] [CrossRef]
- Tsai, Y.-L.; Lin, T.-L.; Chang, C.-J.; Wu, T.-R.; Lai, W.-F.; Lu, C.-C.; Lai, H.-C. Probiotics, prebiotics and amelioration of diseases. J. Biomed. Sci. 2019, 26, 3. [Google Scholar] [CrossRef]
- Altura, B.T.; Altura, B.M. Cardiovascular risk factors and magnesium: Relationships to atherosclerosis, ischemic heart disease and hypertension. Magnes. Trace Elem. 1991, 10, 182–192. [Google Scholar] [PubMed]
- Hii, C.S.T.; Ho, S.L. Effects of flavonoids on insulin secretion and 45Ca2+ handling in rat islets of Langerhans. J. Endocrinol. 1985, 107, 1–8. [Google Scholar] [CrossRef] [PubMed]
- Hou, D.; Yousaf, L.; Xue, Y.; Hu, J.; Wu, J.; Hu, X.; Feng, N.; Shen, Q. Mung bean (Vigna radiata L.): Bioactive polyphenols, polysaccharides, peptides, and health benefits. Nutrients 2019, 11, 1238. [Google Scholar] [CrossRef] [PubMed]
- López, M.E.; El-Naggar, A.; Dueñas, T.; Ortega, M.; Estrella, T.; Hernández, I.; Gómez-Serranillos, M.P.; Palomino, O.M.; Carretero, M.E. Effect of cooking and germination on phenolic composition and biological properties of dark beans (Phaseolus vulgaris L.). Food Chem. 2013, 138, 547–555. [Google Scholar] [CrossRef] [PubMed]
- Houghton, P.J.; Raman, A. Analysis of crude extracts, fractions and isolated compounds. In Laboratory Handbook for the Fractionation of Natural Extracts; Springer: Berlin, Germany, 1998; pp. 113–138. [Google Scholar] [CrossRef]
- Dah-Nouvlessounon, D.; Adoukonou-Sagbadja, H.; Diarrassouba, N.; Sina, H.; Adjanohoun, A.; Inoussa, M.; Akakpo, D.; Gbenou, J.D.; Kotchoni, S.O.; Dicko, M.H.; et al. Phytochemical analysis and biological activities of cola nitida bark. Biochem. Res. Int. 2015, 2015, 1–12. [Google Scholar] [CrossRef]
- Attien, P.; Sina, H.; Moussaoui, W.; Dadieacute, T.; Chabi, S.K.; Ni, T.D.; Bankole, H.; Kotchoni, S.; Edoh, V.; Vost, G.P.; et al. Prevalence and antibiotic resistance of Staphylococcus strains isolated from meat products sold in Abidjan streets (Ivory Coast). African J. Microbiol. Res. 2013, 7, 3285–3293. [Google Scholar] [CrossRef]
- Bauer, A.W.; Kirby, W.M.; Sherris, J.C.; Turck, M. Antibiotic susceptibility testing by a standardized single disc method. Am. J. Clin. Pathol. 1966, 45, 149–158. [Google Scholar] [CrossRef]
- Lamien-Meda, A.; Lamien, C.E.; Compaoré, M.M.; Meda, R.N.; Kiendrebeogo, M.; Zeba, B.; Millogo, J.F.; Nacoulma, O.G. Polyphenol content and antioxidant activity of fourteen wild edible fruits from Burkina Faso. Molecules 2008, 13, 581–594. [Google Scholar] [CrossRef]
- Dieng, S.I.M.; Fall, A.D.; Diatta-Badji, K.; Sarr, A.; Sene, M.; Sene, M.; Mbaye, A.; Diatta, W.; Bassene, E. Evaluation de l’activité antioxydante des extraits hydro-ethanoliques des feuilles et écorces de Piliostigma thonningii Schumach. Int. J. Biol. Chem. Sci. 2017, 11, 768. [Google Scholar] [CrossRef]
- Scherer, R.; Lemos, M.F.; Lemos, M.F.; Martinelli, G.C.; Martins, J.D.L.; da Silva, A.G. Antioxidant and antibacterial activities and composition of Brazilian spearmint (Mentha spicata L.). Ind. Crops Prod. 2013, 50, 408–413. [Google Scholar] [CrossRef]
- Touitou, Y.; Smolensky, M.H.; Portaluppi, F. Ethics, Standards, and Procedures of Animal and Human Chronobiology Research. Chronobio. Int. 2006, 23, 1083–1096. [Google Scholar] [CrossRef] [PubMed]
- Palsamy, P.; Subramanian, S. Resveratrol, a natural phytoalexin, normalizes hyperglycemia in streptozotocin-nicotinamide induced experimental diabetic rats. Biomed. Pharmacother. 2008, 62, 598–605. [Google Scholar] [CrossRef] [PubMed]
- Chandra, A.; Mahdi, A.A.; Ahmad, S.; Singh, R.K. Indian herbs result in hypoglycemic responses in streptozotocin-induced diabetic rats. Nutr. Res. 2007, 27, 161–168. [Google Scholar] [CrossRef]
- Hafizur, M.I.; Babiker, R.M.; Yagi, R.; Chishti, S.; Kabir, S.; Choudhary, N. The antidiabetic effect of Geigeria alata is mediated by enhanced insulin secretion, modulation of β-cell function, and improvement of antioxidant activity in streptozotocin-induced diabetic rats. J. Endocrinol. 2012, 214, 329–335. [Google Scholar] [CrossRef][Green Version]
- Omedine, K.; Loetitia, M.; Ismael, H.; Alphonse, S. Hypotensive Activity of Tridax Procubens hydro ethanolic extract: Roles of transport of sodium and potassium in Rat Wistar. Am. J. PharmTech Res. 2018, 8, 289–302. [Google Scholar] [CrossRef]

| Compound Group | Class | MBN | MBG |
|---|---|---|---|
| Polyphenolic compounds | Tannins | + | − |
| Catechic tannins | + | − | |
| Gallic tannins | + | − | |
| Flavonoids | + | + | |
| Anthocyanins | + | + | |
| Cyanogen derivatives | − | − | |
| Quinonic derivatives | − | − | |
| Heterosides | Saponosides | + | + |
| Reducing compound | − | + | |
| Mucilage | + | + | |
| O-heterosides | − | − | |
| Terpene compounds | Terpenoids | + | + |
| Extracts | Parameters (mg/mL) | Strain | |||||
|---|---|---|---|---|---|---|---|
| S. aur | P. aer | S. epi | E. coli | C. alb | E. coli O157 | ||
| Ethanolic | CMI | 25 | 12.5 | 3.12 | 12.5 | 12.5 | 25 |
| CMB | 50 | >100 | 6.25 | 100 | 25 | 100 | |
| CMB/CMI | 2 * | - | 2 * | 8 | 2 * | 4 | |
| Hydroethanolic | CMI | 12.5 | 6.25 | 12.5 | 25 | 12.5 | 50 |
| CMB | 25 | >100 | 12.5 | >100 | 25 | 100 | |
| CMB/CMI | 2 * | - | 1 * | - | 2 * | 2 * | |
| Methanolic | CMI | 25 | 12.5 | 12.5 | 3.12 | 12.5 | 25 |
| CMB | 50 | >100 | 12.5 | >100 | 25 | 100 | |
| CMB/CMI | 2 * | - | 1 * | - | 2 * | 4 | |
| Extracts | DPPH | FRAP | ||||
|---|---|---|---|---|---|---|
| %Inh | IC50 (mg/mL) | AAI | %Inh | IC50 (mg/mL) | ||
| MBN | Ethanolic | nd | - | - | 77.51 ± 0.71 | 26.33 ± 0.57 |
| Water–ethanol | 85.70 ± 0.06 | 28.65 ± 0.21 | 1.74 ± 0.01 | 81.9 ± 0.01 | 34.66 ± 0.57 | |
| Methanolic | 61.80 ± 0.19 | 78.50 ± 2.12 | 0.63 ± 0.01 | 83.40 ± 0.13 | 34.41 ± 0.52 | |
| MBG | Ethanolic | 54.26 ± 0.06 | 80.00 ± 4.24 | 0.62 ± 0.03 | 82.25 ± 0.31 | 22.66 ± 2.08 |
| Water–ethanol | 88.32 ± 0.06 | 32.50 ± 0.70 | 1.53 ± 0.03 | 82.50 ± 0.47 | 11.06 ± 0.40 | |
| Methanolic | 59.41 ± 0.89 | 38.00 ± 0.00 | 1.31 ± 0.00 | 81.06 ± 0.45 | 43.85 ± 0.49 | |
| Reference | BHA | 91.28 ± 0.05 | 2.18 ± 0.47 | 23.43 ± 5.08 | nd | nd |
| Quercetin | nd | nd | nd | 82.29 ± 0.25 | 1.98 ± 0.18 | |
| G1 | G2 | G3 | G4 | G5 | G6 | G7 | ||
|---|---|---|---|---|---|---|---|---|
| Blood glucose treatment | D1 | 113.50 ± 2.59 a | 408.50 ± 6.63 ab | 423.33 ± 44.32 a | 406.66 ± 53.61 a | 459.00 ± 18.17 a | 434.33 ± 22.67 a | 425.00 ± 24.82 a |
| D7 | 105.00 ± 3.46 a | 393.50 ± 13.56 b | 399.66 ± 19.12 a | 283.33 ± 94.69 a | 259.66 ± 84.61 ab | 167.33 ± 39.71 b | 267.00 ± 19.05 b | |
| D14 | 104.00 ± 1.15 a | 422.00 ± 2.30 a | 270.33 ± 71.39 a | 177.00 ± 93.04 a | 113.00 ± 11.06 b | 108.00 ± 2.64 b | 166.50 ± 20.49 c | |
| Average | 107 ± 1.98 D | 408.00 ± 60.03 A | 364.44 ± 34.41 BA | 289.00 ± 53.00 BC | 277.22 ± 56.10 BC | 236.55 ± 51.89 C | 286.16 ± 39.13 BC | |
| F-value | 2.72 | 6.30 | 2.99 | 3.60 | 11.66 | 48.65 | 29.04 | |
| Probability | p > 0.05 | p < 0.05 | p > 0.05 | p > 0.05 | p < 0.05 | p = 0.001 | p < 0.001 | |
| Body weight | D1 | 199.00 ± 8.66 c | 200.00 ± 4.61 a | 199.00 ± 5.29 a | 199.33 ± 14.84 b | 200.33 ± 6.35 b | 199.66 ± 6.88 b | 199.50 ± 8.37 a |
| D7 | 201.00 ± 8.08 b | 199.00 ± 4.61 b | 198.33 ± 6.17 a | 199.66 ± 14.74 b | 201.66 ± 6.11 b | 204.00 ± 4.50 ab | 202.00 ± 8.66 b | |
| D14 | 204.00 ± 8.66 a | 196.50 ± 4.90 c | 200.66 ± 5.92 a | 203.33 ± 14.51 a | 205.33 ± 6.04 a | 207.33 ± 5.69 b | 205.50 ± 8.37 c | |
| Average | 201.33 ± 4.29 A | 198.50 ± 2.41 A | 199.33 ± 2.92 A | 200.77 ± 7.38 A | 202.44 ± 3.18 A | 203.66 ± 3.09 A | 202.33 ± 4.32 A | |
| F-value | 57.00 | 117.00 | 6.50 | 11.57 | 18.10 | 10.23 | 327.00 | |
| Probability | p < 0.001 | p < 0.0001 | p > 0.05 | p < 0.05 | p < 0.01 | p < 0.05 | p < 0.001 |
| Parameters | Groups | ||||||||
|---|---|---|---|---|---|---|---|---|---|
| G1 | G2 | G3 | G4 | G5 | G6 | G7 | F-value | Probability | |
| HB (g/dL) | 19.00 ± 0.00 a | 17.15 ± 0.08 a | 18.63 ± 0.77 a | 17.83 ± 0.78 a | 17.63 ± 0.66 a | 15.86 ± 1.23 a | 18.3 ± 0.98 a | 1.69 | p > 0.05 |
| HT (%) | 58.00 ± 0.00 a | 52.5 ± 0.28 a | 57.00 ± 2.30 a | 54.66 ± 2.33 a | 54.00 ± 2.00 a | 48.66 ± 3.71 a | 56.00 ± 2.88 a | 1.72 | p > 0.05 |
| RBC (g/L) | 6.38 ± 0.00 a | 5.77 ± 0.03 a | 6.24 ± 0.28 a | 6.01 ± 0.25 a | 5.94 ± 0.22 a | 5.33 ± 0.38 a | 6.16 ± 0.31 a | 1.75 | p > 0.05 |
| WBC (g/L) | 5.8 ± 0.76 a | 7.25 ± 0.95 a | 6.66 ± 0.83 a | 6.89 ± 0.94 a | 6.62 ± 1.16 a | 7.44 ± 1.12 a | 6.18 ± 1.00 a | 0.32 | p > 0.05 |
| L (%) | 30.00 ± 2.82 a | 24.00 ± 5.65 b | 20.66 ± 4.16 b | 27.33 ± 12.22 a | 18.00 ± 2.00 b | 20.00 ± 8.66 b | 10.00 ± 2.82 c | 3.12 | p < 0.05 |
| N (%) | 70.00 ± 2.82 d | 76.00 ± 5.65 c | 79.33 ± 4.16 b | 73.00 ± 12.76 d | 81,66 ± 2.51 b | 79.66 ± 8.96 b | 90.00 ± 2.82 a | 2.75 | p < 0.05 |
| E (%) | 00.00 ± 0.00 a | 00.00 ± 0.00 a | 00.00 ± 0.00 a | 00.00 ± 0.00 a | 00.00 ± 0.00 a | 00.00 ± 0.00 a | 00.00 ± 0.00 a | 0.18 | p > 0.05 |
| M (%) | 00.00 ± 0.00 a | 00.00 ± 0.00 a | 00.00 ± 0.00 a | 00.00 ± 0.00 a | 00.00 ± 0.00 a | 0.33 ± 0.57 a | 00.00 ± 0.00 a | 0.16 | p > 0.05 |
| Lipid Parameters Sought | |||
|---|---|---|---|
| Total Cholesterol (mmol/L) | Total Triglyceride (mmol/L) | LDL (mmol/L) | |
| G1 | 3.41 ± 0.05 e | 3.74 ± 0.01 d | 0.20 ± 0.01 d |
| G2 | 4.37 ± 0.05 a | 4.80 ± 0.01 a | 0.51 ± 0.01 a |
| G3 | 4.08 ± 0.01 b | 4.56 ± 0.02 b | 0.32 ± 0.01 b |
| G4 | 3.90 ± 0.02 c | 4.29 ± 0.02 c | 0.27 ± 0.01 c |
| G5 | 3.53 ± 0.01 d | 3.67 ± 0.02 d | 0.26 ± 0.01 c |
| G6 | 3.36 ± 0.02 e | 3.58 ± 0.01 e | 0.23 ± 0.01 cd |
| G7 | 3.52 ± 0.01 d | 3.72 ± 0.04 d | 0.25 ± 0.00 c |
| F-value | 177.98 | 430.93 | 88.57 |
| Probability | p < 0.001 | p < 0.001 | p < 0.001 |
| Hepatic Parameters | Renal Parameters | |||
|---|---|---|---|---|
| ASAT (U.I/L) | ALAT (U.I/L) | Urea (g/L) | Creatine (mg/L) | |
| G1 | 109 ± 4.04 a | 86 ± 7.50 a | 0.25 ± 0.06 b | 8.40 ± 1.84 b |
| G2 | 123 ± 0.00 a | 91 ± 5.19 a | 0.52 ± 0.00 a | 16.55 ± 0.20 a |
| G3 | 96.66 ± 4.33 ba | 88.33 ± 6.93 a | 0.44 ± 0.06 ba | 13.36 ± 1.70 ba |
| G4 | 70.33 ± 12.91 b | 64.33 ± 13.48 a | 0.29 ± 0.03 ba | 9.2 ± 0.90 ba |
| G5 | 105.66 ± 3.48 a | 89.66 ± 8.41 a | 0.35 ± 0.09 ba | 10.86 ± 2.85 ba |
| G6 | 72.66 ± 9.52 b | 67.66 ± 10.72 a | 0.34 ± 0.02 ba | 13.7 ± 0.81 ba |
| G7 | 99 ± 1.73 ba | 85 ± 2.30 a | 0.36 ± 0.02 ba | 11.85 ± 1.01 ba |
| F-value | 7.41 | 1.55 | 2.90 | 3.21 |
| Probability | p = 0.001 | p > 0.05 | p > 0.05 | p < 0.05 |
| TChol | TryG | LDL | HB | HT | RBC | WBC | Urea | Créa | ASAT | |
|---|---|---|---|---|---|---|---|---|---|---|
| TryG | 0.977 0.000 *** | |||||||||
| LDL | 0.868 0.000 *** | 0.821 0.000 *** | ||||||||
| HB | 0.033 0.886 ns | 0.058 0.801 ns | −0.185 0.422 ns | |||||||
| HTE | 0.036 0.877 ns | 0.061 0.794 ns | −0.186 0.420 ns | 1.000 0.000 *** | ||||||
| NR | 0.036 0.877 ns | 0.057 0.806 ns | −0.185 0.422 ns | 0.999 0.000 *** | 0.999 0.000 *** | |||||
| NB | 0.183 0.427 ns | 0.115 0.618 ns | 0.147 0.525 ns | 0.033 0.889 ns | 0.033 0.886 ns | 0.031 0.893 ns | ||||
| Urea | 0.564 0.008 ** | 0.490 0.024 * | 0.637 0.00 2 ** | −0.082 0.725 ns | −0.081 0.726 ns | −0.077 0.741 ns | 0.148 0.521 ns | |||
| Creatine | 0.428 0.053 ns | 0.363 0.106 ns | 0.563 0.008 ** | −0.205 0.374 ns | −0.207 0.368 ns | −0.204 0.376 ns | 0.059 0.801 ns | 0.926 0.000 *** | ||
| ASAT | 0.291 0.201 ns | 0.261 0.254 ns | 0.473 0.030 * | 0.260 0.254 ns | 0.256 0.263 ns | 0.268 0.240 ns | −0.192 0.405 ns | 0.315 0.165 ns | 0.219 0.340 ns | |
| ALAT | 0.132 0.570 ns | 0.145 0.532 ns | 0.245 0.285 ns | 0.320 0.158 ns | 0.318 0.160 ns | 0.325 0.151 ns | −0.124 0.593 ns | 0.209 0.364 ns | 0.106 0.648 ns | 0.844 0.000 *** |
Publisher’s Note: MDPI stays neutral with regard to jurisdictional claims in published maps and institutional affiliations. |
© 2022 by the authors. Licensee MDPI, Basel, Switzerland. This article is an open access article distributed under the terms and conditions of the Creative Commons Attribution (CC BY) license (https://creativecommons.org/licenses/by/4.0/).
Share and Cite
Kabré, J.d.W.; Dah-Nouvlessounon, D.; Hama-Ba, F.; Agonkoun, A.; Guinin, F.; Sina, H.; Kohonou, A.N.; Tchogou, P.; Senou, M.; Savadogo, A.; et al. Mung Bean (Vigna radiata (L.) R. Wilczek) from Burkina Faso Used as Antidiabetic, Antioxidant and Antimicrobial Agent. Plants 2022, 11, 3556. https://doi.org/10.3390/plants11243556
Kabré JdW, Dah-Nouvlessounon D, Hama-Ba F, Agonkoun A, Guinin F, Sina H, Kohonou AN, Tchogou P, Senou M, Savadogo A, et al. Mung Bean (Vigna radiata (L.) R. Wilczek) from Burkina Faso Used as Antidiabetic, Antioxidant and Antimicrobial Agent. Plants. 2022; 11(24):3556. https://doi.org/10.3390/plants11243556
Chicago/Turabian StyleKabré, Jeanne d’Arc Wendmintiri, Durand Dah-Nouvlessounon, Fatoumata Hama-Ba, Abiola Agonkoun, Felix Guinin, Haziz Sina, Arnaud N. Kohonou, Pascal Tchogou, Maximin Senou, Aly Savadogo, and et al. 2022. "Mung Bean (Vigna radiata (L.) R. Wilczek) from Burkina Faso Used as Antidiabetic, Antioxidant and Antimicrobial Agent" Plants 11, no. 24: 3556. https://doi.org/10.3390/plants11243556
APA StyleKabré, J. d. W., Dah-Nouvlessounon, D., Hama-Ba, F., Agonkoun, A., Guinin, F., Sina, H., Kohonou, A. N., Tchogou, P., Senou, M., Savadogo, A., & Baba-Moussa, L. (2022). Mung Bean (Vigna radiata (L.) R. Wilczek) from Burkina Faso Used as Antidiabetic, Antioxidant and Antimicrobial Agent. Plants, 11(24), 3556. https://doi.org/10.3390/plants11243556

